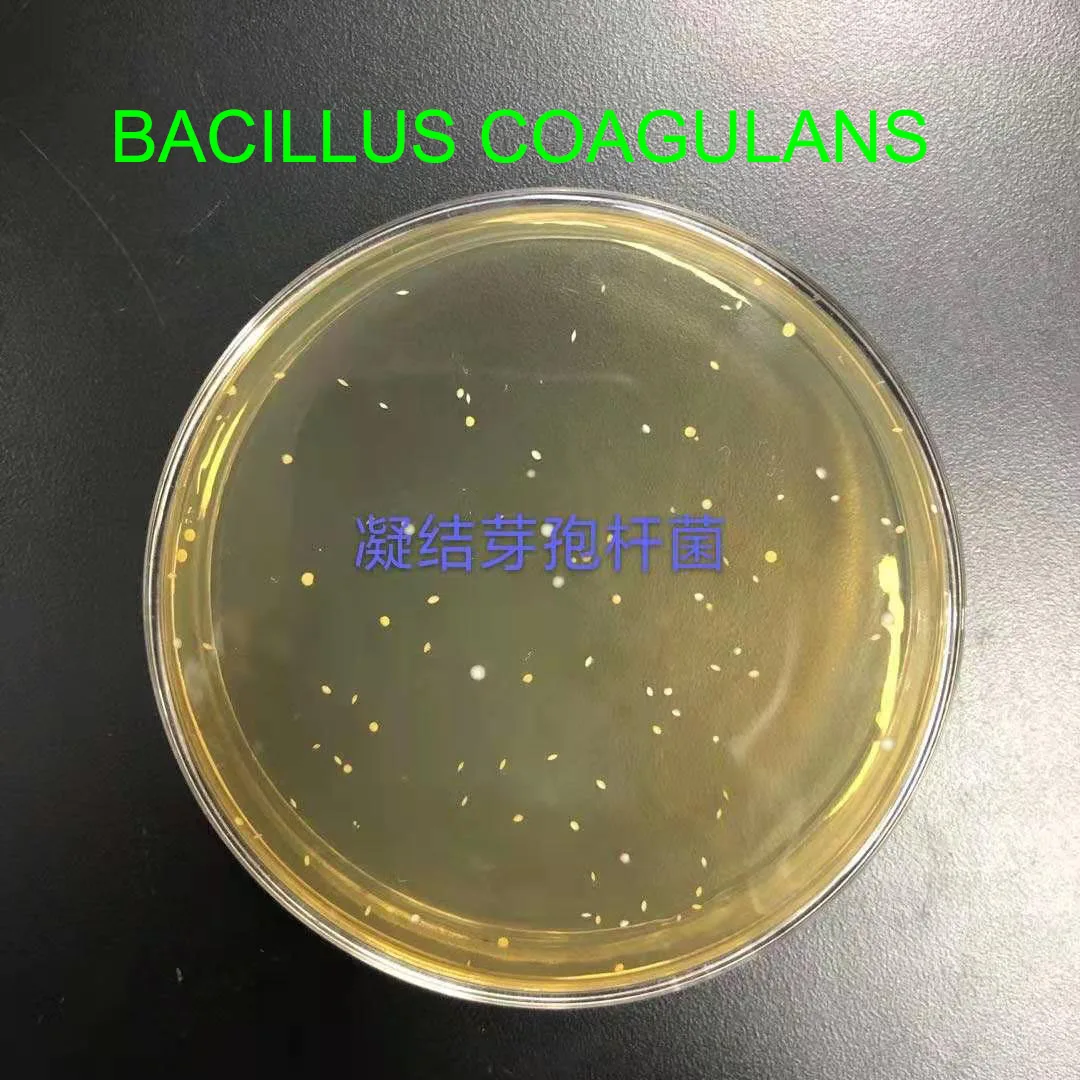

Oem Service Improve Animal Feed Intake 50 Billion Additives Probiotics Powder Bacillus Coagulans Poultry Feed Concentrate
- Category: >>>
- Supplier: Shandong Yihao Biotechnology Co. Ltd.Shandong Ltd.
Share on (1601155321526):
Product Overview
Description
Bacillus coagulans for animals

[Main ingredients] Bacillus coagulans, carrier protective agent
[Product Specifications]
| 20 billion CFU/g |
| 10 billion CFU/g |
| 5 billion CFU/g |
[Product properties] Solid powder
[ Product Features ]
This strain has the characteristics of high temperature resistance, strong stress resistance, strong acid production capacity, high activity, by the company's unique fermentation process, the product is stable and efficient.
[ Function ]
1, high temperature resistance, acid resistance, bile salt resistance, not affected by feed granulation temperature and livestock stomach acid, bile salt, has a strong colonization ability;
2. It has strong lactic acid production ability and significant antibacterial effect. Antibacterial coagulin produced during the growth of bacteria and lactic acid together inhibit the growth of harmful bacteria such as Escherichia coli and Salmonella and reduce intestinal inflammation;
3, secrete amylase, protease and other enzymes, promote the body's digestion and absorption of nutrients, improve feed utilization, and reduce the production of harmful gases such as ammonia and hydrogen sulfide in livestock and poultry excrement;
4, improve the immune function, enhance the resistance of livestock and poultry, alleviate the stress reaction caused by harsh environment, high temperature, weaning, herd switching, vaccination, etc.;
5. Increase the content of volatile fatty acids in the hindgut, improve the fat content and water power in the muscle space, and improve the flavor and quality of livestock and poultry meat.
[ Scope of application ] This product is suitable for feed addition and livestock and poultry breeding.
[ Instruction ]
Feed addition: diluted step by step directly added to livestock and poultry feed, with 10 billion CFU/g products as an example, per ton of full price compound feed: pig feed added 20-50g, a week before and after weaning piglets, according to 50-100g per ton added, can prevent diarrhea; Add 30g/ ton of poultry feed.
[ Note ]
1. Do not use with fungicides, antibiotics, disinfectants;
2. Store in a cool place away from light, avoid strong light exposure;
3. The products that have not been used up after opening should be sealed in time.
[Technical Service]
SHANDONG YIHAO BIOTECHNOLOGY CO.,LTD can help our valued customers to use this product directly!
Our mission is technology, biological and environmentally friendly!
OUR SERVICE

| FAQ |
Q1:Are you manufacturer or trader ?
A1:We are manufacturer. Our factory is located in Weifang city,Shandong province,China. Welcome to visit our factory at any time. |
Q2: What's the MOQ?
A2: It is 1kg/bag or 25kg/bag |
Q3: How long is your delivery time?
A3: Generally, it will take 7 -10 days after receiving payment receipt. |
Q4:What is the payment terms?
A4:Alibaba Trade Assurance ,T/T. Western Union,MoneyGram,Alipay,PayPal etc. |
Q5:Can you accept customization?
A5:Sure, we offer OEM or ODM service. The label and packaging can be made as your requirements. |
Q6: How do you control the quality?
A6: First, we will test every raw materials before manufacture.And after each manufacturing step, our QC team will test again, and then all the manufacturing process finished, we will do the final test before the shipping. |
Q7: How about your service?
A7: We provide 7*12 hours service and one to one business communication,convenient one-station purchasing and excellent after-sale service. |
Why choose us? |
1) Quality first with competitive price!
|
2) Customer first with excellent service!
|
3) Delivery in time!
|
4) OEM service and make to order
|
5)Online technical service for perfect application of goods!
|
CONTACT US :SERVICE ONLINE |
SHANDONG YIHAO BIOTECHNOLOGY CO.,LTD |
Aimee Liu Sales Manager Tel:15153678677 |

CERTIFICATION

 |  |  |
 |  |  |
We Recommend
New Arrivals
New products from manufacturers at wholesale prices